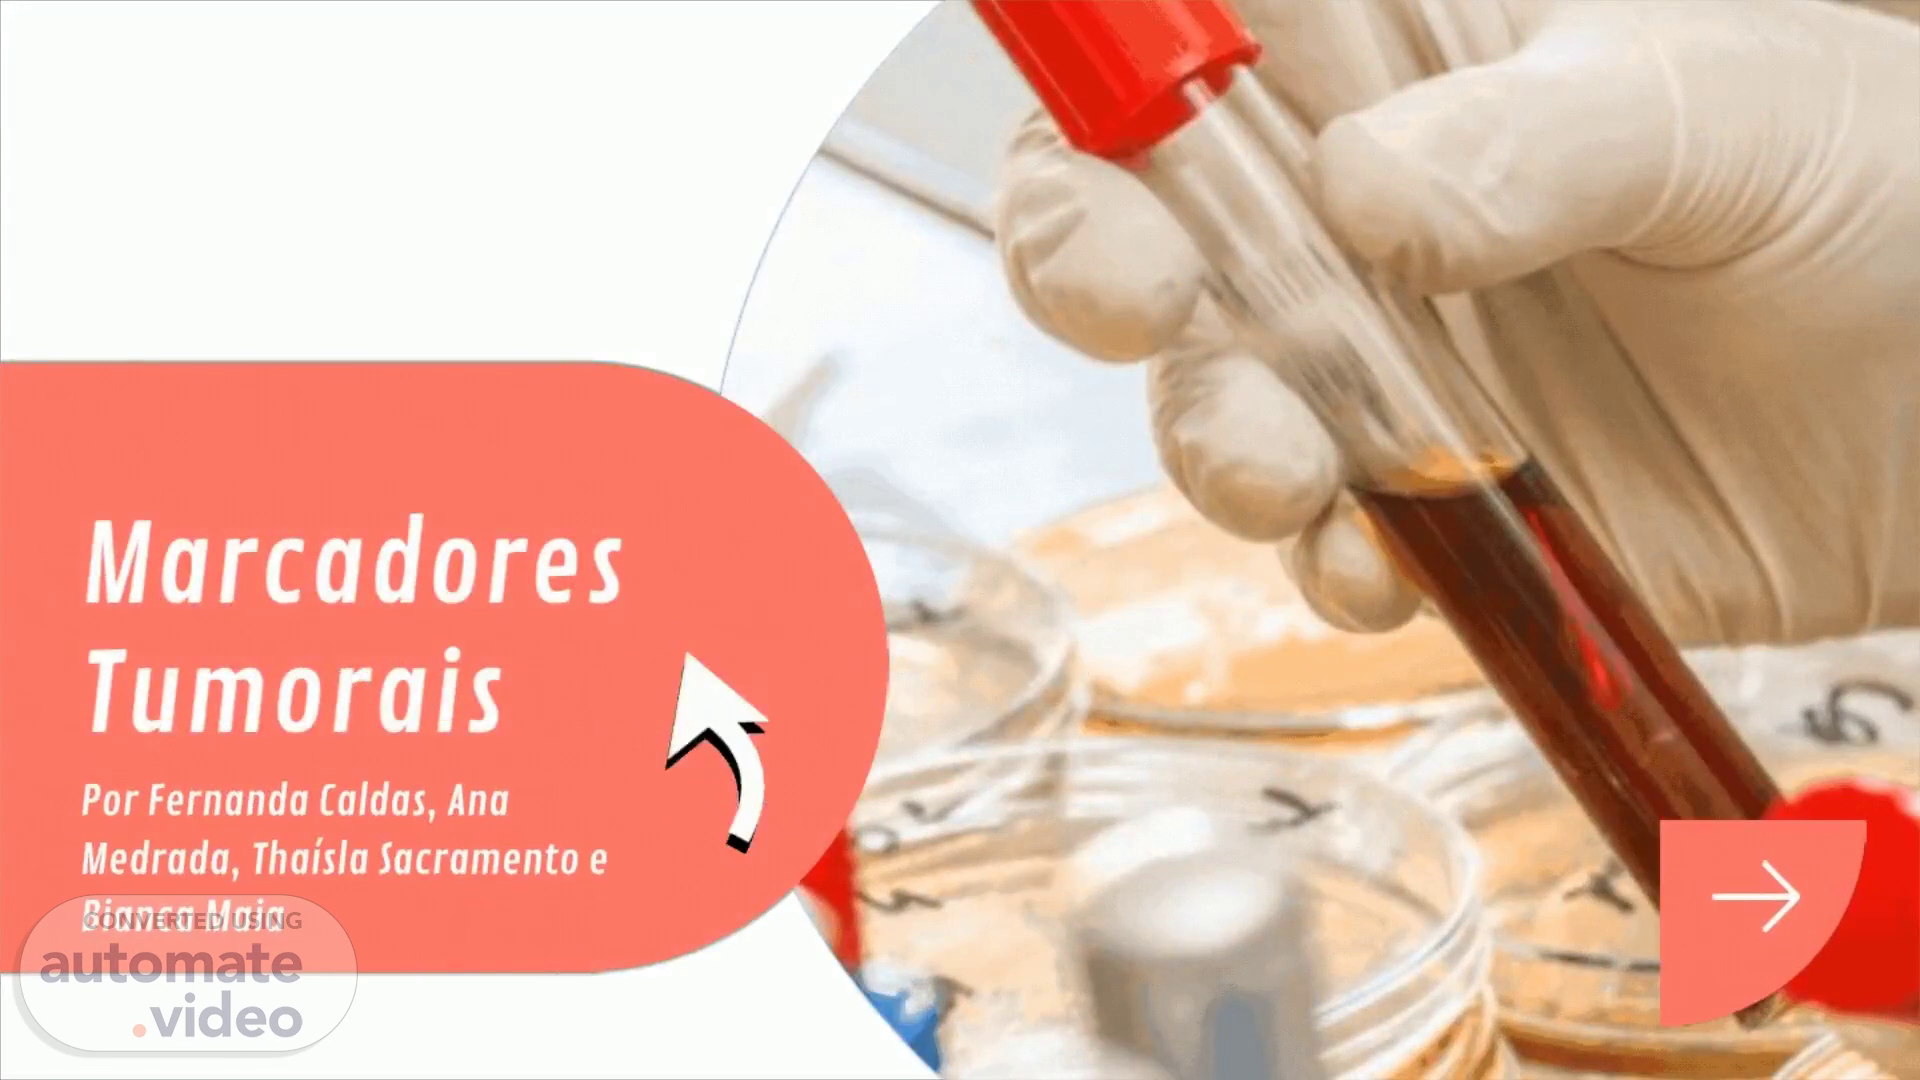

O que são?. Substâncias produzidas por células neoplásicas ou por células normais.
O que precisa para considerar um marcador “ideal”?.
Um marcador sozinho define diagnóstico?. Não, mas auxilia no diagnóstico.
Fosfatase Alcalina. Distribuída em todos os tecidos.
Alfa Fetoproteína. Glicoproteína oncofetal. Encontrada no soro fetal.
Antígeno tumoral 125. Produzido por tecidos do epitélio celômico.
Antígeno carcinoembriônico (CEA). Elevado em aproximadamente um terço dos pacientes portadores de câncer primário do estômago.
Desidrogenase lática (LDH). Esta enzima não tem muito valor diagnóstico, mas relaciona-se com o volume da neoplasia, podendo apresentar implicações prognósticas muito importantes.
β-HCG (gonadotrofina coriônica humana). Esta glicoproteína também é usada como teste de gravidez, pois detecta gravidez normal após sete dias de implantação.
. Paraproteínas. Proteínas monoclonais. Marcadores para Mieloma (Tumor maligno de células plasmáticas).
. Prolactina. Marcador para tumores na hipófise. Hormônio produzido pela hipófise anterior.
. Antígeno Prostático Específico (PSA). Glicoproteína.